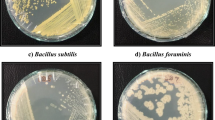

Abstract
Screening for tolerant and high biomass producing plants is important for phytoextraction efforts in remediating agricultural soils contaminated by heavy metals. We carried out a greenhouse experiment involving a soil cadmium (Cd) concentration gradient (0.1, 0.5, 1, 2, 4, and 8 mg kg−1) to assess growth and phytoextraction capacity of king grass (Pennisetum sinese Roxb.) in soils contaminated by Cd and to explore changes in diversity and structure of rhizosphere soil bacterial communities in response to long-term Cd pollution. A significant positive relationship was observed between Cd concentrations in P. sinese stems, leaves, and roots and soil Cd concentration. The highest Cd concentrations in shoots and roots were 28.87 and 34.01 mg kg−1, respectively, at 8 mg kg−1of soil Cd supply. Total extraction amounts of Cd in P. sinese were 0.22–1.86 mg plant−1 corresponding to treatment with 0.5–8 mg kg−1 Cd. Most of the Cd was stored in shoots, and the largest accumulation was 1.56 mg plant−1 with 54.02 g dry shoot weight. After phytoextraction, changes in rhizobacterial community composition were found with different levels of Cd application, whereas there were no clear trends in diversity and richness. Results of this study show the feasibility of P. sinese in accumulating Cd and provide support for its application in remediation of soil moderately contaminated by Cd.
Similar content being viewed by others
Explore related subjects
Discover the latest articles, news and stories from top researchers in related subjects.Avoid common mistakes on your manuscript.
Introduction
In recent years, soil cadmium (Cd) pollution has become one of the most noteworthy global environmental issues because of the high toxicity of the metal and its threats to agricultural security and human health (Li et al. 2010; Xiao et al. 2013). In China, a national investigation found that Cd content in soil in 7.0% of sites sampled exceeded the national safety threshold and that it ranked first among the eight inorganic pollutants for exceeding acceptable levels (MEP and MLR 2014). Therefore, it is of vital importance to remove Cd from contaminated soils.
Phytoextraction, which uses hyperaccumulators or accumulators to clean up heavy metals, is a promising in situ remediation technique because of its cost-effective and environmentally friendly characteristics. Efficient transfer of heavy metals from soil to the plant shoot and high biomass are two crucial traits in plant species for developing effective phytoextraction (Garbisu and Alkorta 2001). However, many verified Cd hyperaccumulators, such as Sedum alfredii (Zhu et al. 2012) and Arabidopsis halleri (McGrath et al. 2006), have shown unsatisfactory results owing to their small biomass or slow growth. Therefore, some studies have concentrated on identifying fast-growing species with higher biomass and strong tolerance towards heavy metals (Lu et al. 2014a; Sun et al. 2009).
King grass (Pennisetum sinese), a perennial hybrid giant Napier grass species used as a bioenergy source, has adequate yield with well-developed roots and strong tillering ability (Lu et al. 2014b). P. sinese was selected for this study because its biomass is harvested every year. In addition, it displays a number of characteristics suitable for phytoextraction of Cd from heavy metal-polluted soils. For instance, Zhang et al. (2014) reported that leaves of P. sinese had no visual toxicity symptoms and that the species could remove 0.94–1.31 kg ha−1 of Cd with 28–79 t ha−1 of dry biomass under 8–100 mg kg−1 of soil Cd. Moreover, P. sinese was more effective at removing Cd than Sedum plumbizincicola or Chrysopogon zizanioides (Cui et al. 2016). However, such studies have been conducted usually under conditions where Cd pollution was caused by the new introduction of exogenous substances or soil amendments applied to soil. Phytotoxicity of metals in these studies may be different from that of metals occurring in the natural environment, and results may overestimate the phytoextraction capacity of P. sinese. Therefore, it is necessary to explore the performance of this species under Cd stress levels more similar to those found in nature.
Up to now, the ultimate purpose of the phytoextraction process has been to restore soil capacity by removing pollutants (Epelde et al. 2008; Jusselme et al. 2013). The recovery state of soil health derived from phytoextraction should be close to the conditions of a target soil (i.e., similar unpolluted soil populated by the plant). Therefore, appropriate indicators are required to evaluate the soil environment and its quality and the success of the phytoextraction process. Soil microorganisms are good candidates in this regard as they show higher sensitivity to heavy metals than soil animals or plants under the same stress (Epelde et al. 2009). Furthermore, the structure and diversity of the microbial community are good indicators of the effects of heavy metal stress on soil ecology (Zhang et al. 2016). Our previous study found that ammonium chloride (NH4Cl) enhanced bacterial and actinomycete activities after P. sinese phytoextraction in soil contaminated by Cd, Pb, and Zn (Chen et al. 2017). However, an in-depth understanding of the influence of Cd stress on the soil bacterial community following phytoextraction is lacking. High-throughput sequencing of 16S rRNA, such as 454 pyrosequencing and MiSeq sequencing, is an optimal tool for studying soil microbial communities and small changes in diversity (Deng et al. 2015; Li et al. 2014).
We aimed to study the growth of P. sinese under different levels of Cd pollution and its tolerance and accumulation of the metal and to explore the response of the rhizosphere bacterial community to Cd toxicity. We hypothesized that (1) elevated Cd would reduce shoot biomass but increase Cd concentration in P. sinese, (2) the efficiency of P. sinese for extracting Cd would differ between Cd treatments, and (3) Cd exposure would reduce the diversity of soil microbial organisms and change microbial community structure.
Materials and methods
Site description and soil characterization
A greenhouse experiment was conducted at Fujian Agricultural and Forestry University (FAFU, 119° 13′ 56″ E, 26° 06′ 20″ N), Fujian Province, China. The experiment used topsoil (0–20 cm) collected from Minhou County in Fuzhou. After air-drying, the soil was pulverized with a hammer and sieved (< 2 mm) before storage. Its texture was loamy clay, consisting of 43.35% clay, 31.49% silt, and 25.15% sand. Other selected parameters were soil pH level of 4.81, organic matter concentration of 19.52 g kg−1, cation-exchange capacity of 12.13 cmol kg−1, free iron oxide concentration of 10.09 g kg−1, and total Cd concentration of 0.10 mg kg−1.
Experiment designs
Plastic basins (upper diameter = 265 mm, lower diameter = 200 mm, height = 240 mm), filled with 7 kg of air-dried soil, were used as potting containers. The soil was first spread on a plastic tray, and then aqueous solution of Cd2+ was sprayed to the soil layer with repeated mixing using a stainless steel shovel. The spiked soils were mixed again for another 5–10 min using an electric agitator and sieved again through a 2-mm mesh to ensure homogeneity. Treated soils were packed again into the containers. Six levels of Cd (0, 0.5,1, 2, 4, and 8 mg kg−1) were added to the soil using a solution containing cadmium acetate. A similar method was reported by Wu et al. (2010). Each treatment consisted of three replicates (N = 18). Those treated soils were placed and stabilized for 4-year duration of the experiment. We selected uniform and healthy intermodal cuttings of P. sinese, which were transplanted two cuttings per pot. Fertilizer was applied at an amount equivalent to 0.2 g N kg−1 soil, containing N:P2O5:K2O = 2:1:1.5. Moisture content of soils was maintained at 70–85% by watering every day. The pots were placed randomly in the greenhouse and kept free of weeds and pests throughout the experimental period. The experiment with the cultivation of P. sinese, starting on April 18, 2015, involved a total growth period of 102 days.
Physicochemical analysis of plant tissue and soil
When P. sinese leaves began to turn yellow at maturity, the whole plants were dug up and divided into leaves, stems (culms), and roots (including rhizomes). All plant samples were washed thoroughly with deionized water and then oven-dried at 75 °C to constant weight. Dry plant samples were weighed for biomass determination, ground, and stored in plastic bags for chemical analysis. Ground plant parts were digested with a concentrated acid mixture of HNO3:HClO4 (4:1, V/V) for tissue Cd determination.
After gathering plant samples, soil samples of each pot were collected, air-dried, and ground for analysis. Basic physicochemical properties were measured according to Jackson (1985). Soil pH level was measured by a pH meter (SevenCompact™ S210, Mettler-Toledo AG, Analytical CH-8603, Schwerzenbach, Switzerland) in a suspension of decarbonated distilled water with soil:water ratio of 1:2.5 (W/V). Soil available Cd was extracted using diethylene triamine pentaacetic acid (DTPA) with soil:liquid ratio of 1:5 (W/V).
Cd concentrations of the plant and soil extracts were determined by inductively coupled plasma mass spectrometry (ICP-MS, NexION 300, PerkinElmer, San Jose, CA, USA). A certified plant reference material (GBW10020, National Research Center for Certified Reference Materials, China) and a soil reference material (GBW07415a) were included in plant and soil sample analysis, respectively. In addition, both analytical contained blanks in digestion batches to ensure accuracy of analytical data.
Soil microbial analysis
Rhizosphere soil samples, tightly attached to roots, were collected as described by Baudoin et al. (2003). They were then freeze-dried and sealed in plastic bags at − 80 °C until analysis. Organic carbon (Corg), total nitrogen (Nt), total sulfur (St), and carbon/nitrogen ratio (C/N) of soil samples were analyzed with a CNS analyzer (Elementar Vario MAX cube, Elementar, Germany). Soil DNA was extracted from 0.25 g of fresh rhizosphere soil with MO BIO PowerSoil® DNA Isolation kit (MO BIO Laboratories, Carlsbad, CA, USA) and 16S rRNA was amplified in a polymerase chain reaction (PCR). PCR amplification was carried out in 2 × 25 μl reaction mixtures containing 1 μl of 909R, 2.5 μl of 1× PCR buffer, 2 μl of dNTP, 2 μl of MgCl2, 0.17 μl of Tag polymerase, 15.33 μl of sterilized water, 1 μl of 515, and 1 μl of DNA. The PCR cycle was run as an initial denaturation of 3 min at 94 °C, 30 cycles of 40 s at 94 °C, 60 s at 56 °C, 60 s at 72 °C, and a final elongation of 10 min at 72 °C. After PCR amplification with 25 μl of reaction mixture and electrophoresis with 1.0% agarose gel, the targeted gene fragment band was separated and purified using the SanPrep DNA Gel Extraction Kit (Sangon Biotech, Shanghai, China). The concentration and quality of DNA were detected by using a NanoDrop 2000 spectrophotometer (Thermo Fisher Scientific Inc., Shanghai, China) to observe the ratio of A260/A280. Extracted DNA was diluted to 10 ng μl−1 and stored at − 40 °C for downstream use. All samples were pooled together in a single tube with an equal molar amount from each sample. The mixture was then sent to a specialized agency for testing.
Universal primers used to span the V4 region of the 16S rRNA genes in PCR were 515F (5′-GTGCCAGCMGCCGCGGTAA-3′) and 909R (5′-CCCCGYCAATTCMTTTRAGT-3′) (Caporaso et al. 2012, 2011). Bacterial 16S rRNA genes were sequenced on an Illumina Miseq sequencer and data were assembled with QIIME Pipeline (version 1.7.0 (http://qiime.org/)). Read lengths of > 150 bp and average base quality scores of > 30 were considered high-quality sequences for downstream analysis. Operational taxonomic units (OTUs) were classified at a 97% identity threshold. Sequence depth was randomly resampled to 9566 reads.
Statistical analysis
Translocation factor (TF), bioconcentration factor (BCF), and Cd extraction amounts were used to evaluate efficiency of phytoextraction (Wu et al. 2010). Data were presented as mean values of three repeat samples and were analyzed using one-way ANOVA with IBM SPSS Statistics 19. Tukey’s test was used for multiple means comparison at the 5% significance level.
For pyrosequencing-derived data, α-diversity of the bacterial community (Chao1 species richness and Simpson’s and Shannon’s diversity indices) was generated from the number of OTUs. Correlations between microbial diversity and soil properties were tested using Pearson’s correlation coefficient. Principal coordinate analysis (PCoA) based on UniFrac distance matrices was carried out to observe community relationships. The relationship between bacterial community composition and soil characteristics was analyzed with redundancy analysis (RDA) in Canoco for Windows 4.5.
Results
Plant growth in response to Cd stress
Dry weights of leaves, stems, and roots in the control (CK) were 48.50, 40.39, and 11.59 g plant−1, respectively (Fig. 1). Cd application significantly decreased dry weights of leaves and stems compared to the control (P < 0.05), but there were no statistically significant differences between Cd treatment levels (P > 0.05) in root dry weight. This result was confirmed by linear regression analysis between dry weights of roots, stems, or leaves of P. sinese and total or DTPA-extractable Cd concentration in soil (Fig. 2). The highest concentration (8 mg kg−1) only led to reductions in dry weights by 32.5, 47.3, and 29.6% in leaves, stems, and roots, respectively. This result suggests that P. sinese has a high tolerance for Cd. In all Cd treatment levels, biomass allocation to leaves was highest and to roots was lowest (with intermediate allocation to stems). The shoot:root ratio (S/R) was greater than one, showing that biomass was mainly allocated to P. sinese shoots, and ranged from 86 to 89%.
Cd concentration in different parts of P. sinese
Roots generally exhibited the highest Cd concentration, followed by stems and leaves; however, Cd concentration in stems was higher than that in roots at the highest Cd application rate of 8 mg kg−1 (Fig. 3). Cd concentrations in different parts of P. sinese (roots, stems, and leaves) increased with increasing soil Cd levels (P < 0.05). A significant positive linear correlation was found between Cd concentrations in plant tissues and total or DTPA-extractable Cd concentrations in soils (Fig. 4). When the soil Cd concentration reached 8 mg kg−1, root, stem, and leaf concentrations of Cd reached 34.01, 39.93, and 21.70 mg kg−1, respectively, a 29-, 61-, and 53-fold increase compared to those of the control. In addition, Cd concentrations in shoots and roots ranged from 0.51 to 28.87 and 1.12 to 34.01 mg kg−1, respectively (Table 1). Mean Cd concentration in roots was higher than that in shoots in all treatments.
Cd extraction efficiency of P. sinese
The major extraction amount of Cd was stored in stems, followed by in leaves, whereas only minor amounts accumulated in roots (Fig. 5). In the control treatment, Cd extraction amounts in shoots and roots were 0.05 and 0.01 mg plant−1, respectively. The Cd extraction amount in shoots contributed over 83% to the total Cd extraction amount. Compared to the control, total extraction amounts increased with increasing Cd concentration in the soil, from 0.22 mg Cd per plant in the Cd0.5 treatment to 1.86 mg Cd per plant in the Cd8 treatment. In addition, in all Cd treatments, Cd extraction amount in shoots was higher than that in roots, thus TFA > 1. On the other hand, when Cd concentration treated in the soil increased from 0 to 8 mg kg−1, TFC increased from 0.48 to 0.86 while the BCF of the shoots decreased from 5.06 to 3.56 (Table 1). These results indicate appreciable efficiency in translocation of Cd from roots to aboveground parts in P. sinese.
Cadmium extraction amounts (mg per plant) and the root-to-shoot transfer factor (TFA) of the Pennisetum sinese. The Cd extraction amounts were calculated by multiplying the tissue concentration of Cd by the tissue dry weight. TFA is defined as the ratio of the Cd extraction amounts in the shoots to the extraction amounts in the roots
Diversity in the rhizosphere bacterial community
In microbial analysis of the 18 soil samples across the Cd gradient after plant harvesting, diversity indices were calculated based on 16S rRNA sequences with 87.1–88.9% coverage. Compared to the control treatment, the observed species, Chao1 richness estimator, Shannon index, and Simpson index at a cutoff of 3% varied insignificantly in the Cd treatments (P > 0.05), although it was apparent that OTUs and Chao1 in the spiked treatments were generally lower (Table 2). In addition, no significant relationship could be observed between diversity indices and soil Cd concentrations.
PCoA found significant variation in community distributional (β-diversity) of bacterial assemblages (Fig. 6). UniFrac values showed some similarities in the bacterial communities between different sampling groups. However, PerMANOVA based on the unweighted UniFrac metric showed that the differences in bacterial community structure between Cd gradients were significant (P < 0.05). It suggested an obvious separation of the bacterial communities along the Cd gradient, although some samples could not be separated distinctly.
Overall changes in bacterial community structure
Of the classifiable sequences, 29 bacterial phyla and 2 Archaea phyla were identified from the rhizosphere soil samples. In all samples, the Chloroflexi (24.14–35.02%), Actinobacteria (11.50–18.59%), Proteobacteria (13.94–19.89%), Acidobacteria (9.21–16.12%), Cyanobacteria (4.51–20.08%), Firmicutes (0.90–2.22%), Planctomycetes (1.70–9.80%), and Gemmatimonadetes (1.15–1.86%) were the most abundantly represented bacterial phyla, in total 89.1–92.2% of the bacterial community in samples. The other bacterial phyla were less abundant.
RDA was used to identify soil variables with the largest effect on the bacterial community structure (Fig. 7). The first ordination axis was strongly correlated with soil total Cd, DTPA-Cd, and Corg and explained 35.0% of the total variability. The second ordination axis was unrestricted (11.5% of contribution rate) and mainly associated with pH and St. According to results of the Monte Carlo permutation test, soil total Cd (P = 0.024) and Corg (P = 0.032) were the major factors explaining the variations in the overall structure in the study. For example, soil Cd and Corg had a significantly positive effect on the relative abundances of the Cyanobacteria, Bacteroidetes, Verrucomicrobia, and NC10 species, while Actinobacteria, Firmicutes, FBP, and Chloroflexi had the opposite relationship to soil Cd. The Acidobacteria, Actinobacteria, and Firmicutes had large loadings, although not statistically significant, on axis 2 related to pH and St.
Redundancy analysis of rhizosphere soil microbial community composition. Environmental factors include soil total cadmium (Cd), available Cd (DTPA-Cd), soil pH, and organic carbon (Corg), total nitrogen (Nt), and total sulfur (St) content, and carbon/nitrogen ratio (C/N). The ordination diagram shows only those species that can be explained by restricted axis 1
Discussion
Response of the growth and Cd uptake of P. sinese to Cd stress
Previous studies have suggested that normal Cd concentrations in plants often range from 0.05 to 0.2 mg kg−1, and tissue Cd concentrations of 3–10 mg kg−1 dry weight can cause plants to suffer toxic effects (Shi and Cai 2009; Solís-Domínguez et al. 2007). In the current study, P. sinese had toxic concentrations of Cd in shoots (0.51–28.87 mg kg−1) and roots (1.12–34.01 mg kg−1). Nonetheless, P. sinese demonstrated high tolerance of Cd, with only a reduction in biomass and no obvious toxic symptoms such as leaf chlorosis. Cd applications under 2 mg kg−1 did not cause significant reductions in leaf and stem dry weights of P. sinese, and root dry weight was not significantly affected by tested Cd contamination levels. This result is in contrast to observation in its parent plant Napier grass (P. purpureum); Cd stimulated the growth of P. purpureum at concentration below 8 mg Cd kg−1 soil (Zhang et al. 2010b). This could be explained by the differences in toxicity between newly spiked and aging Cd-contaminated soils and the restriction of growing space.
P. sinese took up Cd from contaminated soil and accumulated it in its tissues. In this study, Cd concentrations in stems, leaves, or roots increased linearly with increasing soil Cd concentrations. This indicated that Cd uptake of P. sinese was affected by soil total Cd and available Cd concentrations. In the case of soil available Cd extracted by DTPA (0.11–2.06 mg kg−1), DTPA-extractable Cd concentration increased with increasing total Cd concentration. This is partly due to acidity of the soil and the high mobility of Cd. Application of fertilizer and acidification of root exudates during the growth period decreased soil pH level by at least 0.66. Cd concentrations in P. sinese increased with increasing Cd concentrations in soil, in agreement with results of Lombi et al. (2000).
Cd phytoextraction potential of P. sinese
When assessing the potential of a metal accumulator to remove heavy metals, a BCF greater than 1 is more important than shoot concentration of the metal (Zhao et al. 2003). In P. sinese, Cd concentration in shoot was far below the criterion for Cd hyperaccumulator (> 100 mg kg−1), which might be restricted by the relatively low contaminated levels. Meanwhile, the minimum value for BCF was 3.05, confirming that P. sinese was a Cd accumulator species, rather than a Cd excluder species. Yoon et al. (2006) reported Macleaya cordata could be used as a phytoremediation plant for BCFs in all Cd treatments which were above 1. However, BCF significantly decreased with increasing total Cd in soil. BCF of some Cd hyperaccumulator, such as A. halleri (Zhao et al. 2006) and Thlaspi praecox (Vogel-Mikus et al. 2005), also showed this change.
In addition, higher biomass production can make up for the relatively weak capacity of plants to absorb heavy metals (Rosselli et al. 2003). Perennial energy crops not only can be harvested every year for high yield but also can be used to promote continuous and gradual purification of soils (Kocoń and Jurga 2017). P. sinese was selected for this study because of its high annual biomass yield. In most cases of phytoextraction, shoots are the generally harvestable parts, leaving roots to rot in the soil. Similarly, the shoot is the main component of P. sinese. In P. sinese, biomass is allocated predominantly to shoots and suppression of shoot growth will decrease total biomass. Our findings are similar to the results for a perennial weed Phytolacca americana L. (Liu et al. 2010). In our study, dry weight and Cd extraction amount in shoots reached 54.02 g plant−1 and 1.56 mg plant−1, respectively, at 8 mg kg−1 soil Cd. This Cd extraction amount was higher than amounts observed for some Cd hyperaccumulators. For example, T. caerulescens accumulated 1.48 mg Cd per plant at 100 mg kg−1 soil Cd (Epelde et al. 2008). The highest Cd extraction amount in the shoots of Malva sinensis Cavan. was 0.47 mg per plant when soil Cd reached 125 mg kg−1 (Zhang et al. 2010a). The increase in extraction amount with increasing soil Cd concentration in this study could be explained by high biomass production as well as strong Cd mobility. Our results agree with those of Ma et al. (2016), which found that most of the heavy metal was stored in the stem of Napier grass due to its high biomass. Our results also imply that P. sinese is an interesting candidate for phytoextraction application in Cd-contaminated agricultural soils.
Responses of soil bacteria to Cd pollution
The diversity of bacteria in soil is enormous, and soil bacterial communities can vary greatly in structure. For instance, Sun et al. (2012) reported that heavy metals deposited in estuarine sediments caused strong changes in bacterial community composition and diversity. Khan et al. (2010) found that soil microbial activities were inhibited and that microbial community structure changed in Cd/Pb-amended soils. In the present study, contaminated and uncontaminated (control) soils had very similar values for soil bacterial diversity at the end of the experiment and, therefore, it may be concluded that although Cd pollution changed soil bacterial communities with obvious changes in bacterial relative abundance, bacterial diversity was not significantly altered after phytoextraction. Moreover, the structure of soil bacterial communities depended to the largest extent on soil total Cd. Cd pollution selectively affected the prevalence of several dominant bacterial groups, with the abundance of some phyla, such as the Acidobacteria and Proteobacteria, changing very little, while other phyla, such as the Actinobacteria, Planctomycetes, TM7, WPS-2, and Armatimonadetes, changing significantly across the Cd gradient. This suggests that all the bacterial phyla studied were affected by Cd pollution in some way. Desai et al. (2009) observed a distinct bacterial community shift from the Proteobacteria to the Firmicutes in soils polluted long term with chromium. The structure of soil bacterial communities also depends on organic carbon content; past research has suggested that it changed greatly due to C mineralization (Fierer et al. 2007).
Other studies have also found, via high-throughput sequencing, that long-term nickel (Li et al. 2015) and copper exposure (Berg et al. 2012) altered soil bacterial composition, but not its diversity. Two explanations may be given. Firstly, plants can secrete a variety of organic compounds, such as organic acids, into soil during the course of phytoextraction. Heavy metal ions can combine with these organic acids to form a metal ion-organic acid complex, reducing the toxicity of the metal ion to rhizosphere bacterial populations (ÓDonnell et al. 2001). Secondly, soil aging and leaching reduce bioavailability and toxicity of heavy metals (Guo et al. 2010; Singh et al. 2014). After 4 years with aging, available Cd concentrations in the present study were even lower than the maximum allowed Cd concentration according to the second standard of environmental quality for soils in China (soil pH < 6.5, total soil Cd ≤ 0.3 mg kg−1); therefore, metal toxicity was low enough that it did not significantly change bacterial diversity and richness.
Conclusions
P. sinese, a source of bioenergy with high biomass production, is a species that can be grown on moderately Cd-contaminated soils. Under experimental conditions, Cd concentrations in different parts of P. sinese (roots, stems, and leaves) depended greatly on soil Cd concentrations. Accumulation of Cd was observed mainly in shoots due to their high biomass. This study also showed that, as a result of phytoextraction, long-term Cd exposure had few impacts on rhizosphere soil bacterial diversity and richness, but bacterial community composition changed during soil remediation. In conclusion, P. sinese will be useful for restoring Cd-contaminated sites. Therefore, future studies are needed to explore the nature and enhancement of phytoextraction by this species.
References
Baudoin E, Benizri E, Guckert A (2003) Impact of artificial root exudates on the bacterial community structure in bulk soil and maize rhizosphere. Soil Biol Biochem 35:1183–1192
Berg J, Brandt KK, Al-Soud WA, Holm PE, Hansen LH, Sørensen SJ, Nybroea O (2012) Selection for Cu-tolerant bacterial communities with altered composition, but unaltered richness, via long-term Cu exposure. Appl Environ Microb 78:7438–7446
Caporaso JG, Lauber CL, Walters WA, Berg-Lyons D, Lozupone CA, Turnbaugh PJ, Fierer N, Knight R (2011) Global patterns of 16S rRNA diversity at a depth of millions of sequences per sample. Proc Natl Acad Sci USA 108:4516–4522
Caporaso JG, Lauber CL, Walters WA, Berg-Lyons D, Huntley J, Fierer N, Owens SM, Betley J, Fraser L, Bauer M, Gormley N, Gilbert JA, Smith G, Knight R (2012) Ultra-high-throughput microbial community analysis on the Illumina HiSeq and MiSeq platforms. ISME J 6:1621–1624
Chen Y, Hu L, Liu X, Deng Y, Liu M, Xu B, Wang M, Wang G (2017) Influences of king grass (Pennisetum sinese Roxb.)-enhanced approaches for phytoextraction and microbial communities in multi-metal contaminated soil. Geoderma 307:253–266
Cui H, Fan Y, Yang J, Xu L, Zhou J, Zhu Z (2016) In situ phytoextraction of copper and cadmium and its biological impacts in acidic soil. Chemosphere 161:233–241
Deng L, Zeng G, Fan C, Lu L, Chen X, Chen M, Wu H, He X, He Y (2015) Response of rhizosphere microbial community structure and diversity to heavy metal co-pollution in arable soil. Appl Microbiol Biotechnol 99:8259–8269
Desai C, Parikh RY, Vaishnav T, Shouche YS, Madamwar D (2009) Tracking the influence of long-term chromium pollution on soil bacterial community structures by comparative analyses of 16S rRNA gene phylotypes. Res Microbiol 160:1–9
Epelde L, Becerril JM, Allica JH, Barrutia O, Garbisu C (2008) Functional diversity as indicatorof the recovery of soil health derived from Thlaspi caerulescens growth and metal phytoextraction. Appl Soil Ecol 39:299–310
Epelde L, Mijangos I, Becerril JM, Garbisu C (2009) Soil microbial community as bioindicator of the recovery of soil functioning derived from metal phytoextraction with sorghum. Soil Biol Biochem 41:1788–1794
Fierer N, Bradford MA, Jackson RB (2007) Toward an ecological classification of soil bacteria. Ecology 88:1353–1364
Garbisu C, Alkorta I (2001) Phytoextraction: a cost-effective plant-based technology for the removal of metals from the environment. Bioresour Technol 77:229–236
Guo XY, Zuo YB, Wang BR, Li JM, Ma YB (2010) Toxicity and accumulation of copper and nickel in maize plants cropped on calcareous and acidic field soils. Plant Soil 333:365–373
Jackson ML (1985) Soil chemical analysis: advanced course, 2nd edn. University of Wisconsin, Madison
Jusselme MD, Miambi E, Mora P, Diouf M, Rouland-Lefèvre C (2013) Increased lead availability and enzyme activities in root-adhering soil of Lantana camara during phytoextraction in the presence of earthworms. Sci Total Environ 445-446:101–109
Khan S, Hesham AEL, Qiao M, Rehman S, He J (2010) Effects of Cd and Pb on soil microbial community structure and activities. Environ Sci Pollut Res 17:288–296
Kocoń A, Jurga B (2017) The evaluation of growth and phytoextraction potential of Miscanthus × giganteus and Sidahermaphrodita on soil contaminated simultaneously with Cd, Cu, Ni, Pb, and Zn. Environ Sci Pollut Res 24:4990–5000
Li J, Sun Y, Yin Y, Ji R, Wu J, Wang X, Guo H (2010) Ethyl lactate-EDTA composite system enhances the remediation of the cadmium-contaminated soil by autochthonous willow (Salix × aureo-pendula CL ‘J1011’) in the lower reaches of the Yangtze River. J Hazard Mater 181:673–678
Li X, Rui J, Mao Y, Yannarell A, Mackie R (2014) Dynamics of the bacterial community structure in the rhizosphere of a maize cultivar. Soil Biol Biochem 68:392–401
Li J, Hu H, Ma Y, Wang J, Liu Y, He J (2015) Long-term nickel exposure altered the bacterial community composition but not diversity in two contrasting agricultural soils. Environ Sci Pollut Res 22:10496–10505
Liu X, Peng K, Wang A, Lian C, Shen Z (2010) Cadmium accumulation and distribution in populations of Phytolacca americana L. and the role of transpiration. Chemosphere 78:1136–1141
Lombi E, Zhao FJ, Duniham SJ, McGarth SP (2000) Cadmium accumulation in populations of Thlaspi caerulescens and Thlaspi goesingense. New Phytol 145:11–20
Lu M, Zhang Z, Wang J, Zhang M, Xu Y, Wu X (2014a) Interaction of heavy metals and pyrene on their fates in soil and tall fescue (Festuca arundinacea). Environ Sci Technol 48:1158–1165
Lu Q, Tang L, Wang S, Huang B, Chen Y, Chen X (2014b) An investigation on the characteristics of cellulose nanocrystals from Pennisetum sinese. Biomass Bioenergy 70:267–272
Ma C, Ming H, Lin C, Naidu R, Bolan N (2016) Phytoextraction of heavy metal from tailing waste using Napier grass. Catena 136:74–83
McGrath SP, Lombi E, Gray CW, Caille N, Dunham SJ, Zhao FJ (2006) Field evaluation of Cd and Zn phytoextraction potential by the hyperaccumulators Thlaspi caerulescens and Arabidopsis halleri. Environ Pollut 141:115–125
MEP, MLR (2014) The communique of national investigation of soil contamination. Ministry of environmental protection of the People’s Republic of China. Ministry of Land and Resources of the People’s Republic of China. http://www.mep.gov.cn/gkml/hbb/qt/201404/t20140417_270670.htm
ÓDonnell AG, Seasman M, Macrae A, Waite I, Davies JT (2001) Plants and fertilisers as drivers of change in microbial community structure and function in soils. Plant Soil 232:135–145
Rosselli W, Keller C, Boschi K (2003) Phytoextraction capacity of trees growing on a metal contaminated soil. Plant Soil 256:265–272
Shi G, Cai Q (2009) Cadmium tolerance and accumulation in eight potential energy crops. Biotechnol Adv 27:555–561
Singh BK, Quince C, Macdonald CA, Khachane A, Thomas N, Al-Soud WA, Sorensen SJ, He Z, White D, Sinclair A, Crooks B, Zhou J, Campbell CD (2014) Loss of microbial diversity in soils is coincident with reductions in some specialized functions. Environ Microbiol 16:2408–2420
Solís-Domínguez FA, Gonźalez-Chávez MC, Carrillo-Gonźalez R, Rodŕıguez-Vázquez R (2007) Accumulation and localization of cadmium in Echinochloa polystachya grown within a hydroponic system. J Hazard Mater 141:630–636
Sun Y, Zhou Q, Wang L, Liu W (2009) Cadmium tolerance and accumulation characteristics of Bidens pilosa L. as a potential Cd-hyperaccumulator. J Hazard Mater 161:808–814
Sun SY, Dafforn KA, Brown MV, Johnston EL (2012) Bacterial communities are sensitive indicators of contaminant stress. Mar Pollut Bull 64:1029–1038
Vogel-Mikus K, Drobne D, Regvar M (2005) Zn, Cd and Pb accumulation and arbuscular mycorrhizal colonisation of pennycress Thlaspi praecox Wulf. (Brassicaceae) from the vicinity of a lead mine and smelter in Slovenia. Environ Pollut 133:233–242
Wu F, Yang W, Zhang J, Zhou L (2010) Cadmium accumulation and growth responses of a poplar (Populus deltoids × Populus nigra) in cadmium contaminated purple soil and alluvial soil. J Hazard Mater 177:268–173
Xiao W, Wang H, Li T, Zhu Z, Zhang J, He Z, Yang X (2013) Bioremediation of Cd and carbendazim co-contaminated soil by Cd-hyperaccumulator Sedum alfredii associated with carbendazim-degrading bacterial strains. Environ Sci Pollut Res 20:380–389
Yoon J, Cao X, Zhou Q, Ma LQ (2006) Accumulation of Pb, Cu, and Zn in native plants growing on a contaminated Florida site. Sci Total Environ 368:456–464
Zhang S, Chen M, Li T, Xu X, Deng L (2010a) A newly found cadmium accumulator—Malva sinensis Cavan. J Hazard Mater 173:705–709
Zhang X, Xia H, Li Z, Zhuang P, Gao B (2010b) Potential of four forage grasses in remediation of Cd and Zn contaminated soils. Bioresour Technol 101:2063–2066
Zhang X, Zhang X, Gao B, Li Z, Xia H, Li H, Li J (2014) Effect of cadmium on growth, photosynthesis, mineral nutrition and metal accumulation of an energy crop, king grass (Pennisetum americanum × P. purpureum). Biomass Bioenergy 67:179–187
Zhang W, Chen L, Zhang R, Lin K (2016) High throughput sequencing analysis of the joint effects of BDE209-Pb on soil bacterial community structure. J Hazard Mater 301:1–7
Zhao FJ, Lombi E, McGrath SP (2003) Assessing the potential for zinc and cadmium phytoremediation with the hyperaccumulator Thlaspi caerulescens. Plant Soil 249:37–43
Zhao FJ, Jiang RF, Dunham SJ, McGrath SP (2006) Cadmium uptake, translocation and tolerance in the hyperaccumulator Arabidopsis halleri. New Phytol 172:646–654
Zhu Z, Yang X, Wang K, Huang H, Zhang X, Fang H, Li T, Alva AK, He Z (2012) Bioremediation of Cd-DDT co-contaminated soil using the Cd-hyperaccumulator Sedum alfredii and DDT-degrading microbes. J Hazard Mater 235-236:144–151
Acknowledgements
We thank Prof. Li and his colleague for help with MiSeq sequencing.
Funding
This work was supported by the National Natural Science Foundation of China (41301576) and the Research Fund for science and technology project of Fujian (2017R1004-3). Part of this work was supported by Chengdu Institute of Biology, Chinese Academy of Science.
Author information
Authors and Affiliations
Corresponding author
Additional information
Responsible editor: Elena Maestri
Rights and permissions
About this article
Cite this article
Hu, L., Wang, R., Liu, X. et al. Cadmium phytoextraction potential of king grass (Pennisetum sinese Roxb.) and responses of rhizosphere bacterial communities to a cadmium pollution gradient. Environ Sci Pollut Res 25, 21671–21681 (2018). https://doi.org/10.1007/s11356-018-2311-9
Received:
Accepted:
Published:
Issue Date:
DOI: https://doi.org/10.1007/s11356-018-2311-9